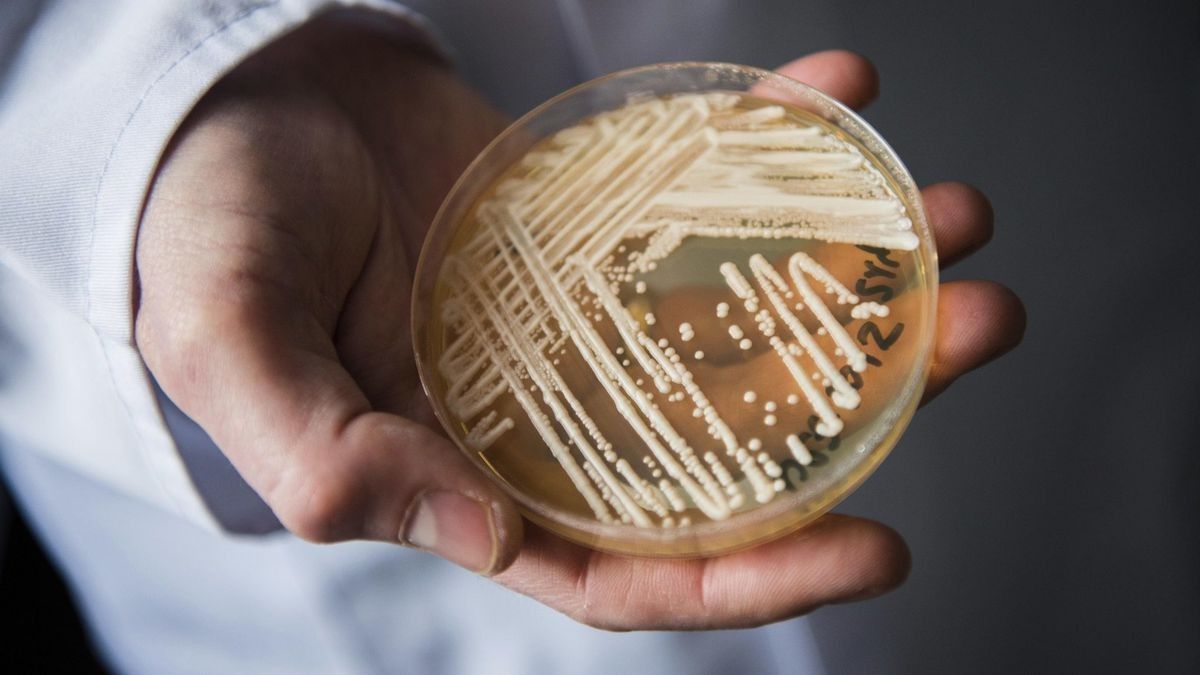
2021/03/MYIFWMYOFBABPOSZIYOAPV37QU.jpg

Një kërpudhë vdekjeprurëse rezistente ndaj shumë ilaçeve gjendet në natyrë
Një kërpudha vdekjeprurëse, rezistente ndaj ilaçeve ekzistuese antifungale, u zbulua së pari jashtë spitalit, në plazhin e një ishulli tropikal të izoluar. Është një kërpudhat Candida auris që në mënyrë misterioze u shfaq në spitale pak më shumë se dhjetë vjet më parë.
"Misteri është nga lindi", tha Dr. Arturo Casadevall, kreu i Departamentit të Mikrobiologjisë Molekulare dhe Imunologjisë në Shkollën e Shëndetit Publik të Baltimore, sipas portalit ScienceAlert.
Zbulimi i ri, i botuar në revistën mjekësore mBio, mund të ndihmojë në parandalimin dhe kontrollimin e përhapjes së saj, transmeton Telegrafi.
Candida auris u zbulua për herë të parë në vitin 2009 tek një pacient në Japoni dhe u përhap shpejt në të gjithë botën. Mikrobi mund të shkaktojë infeksione në qarkullimin e gjakut, sipas Qendrave të Kontrollit dhe Parandalimit të Sëmundjeve të SHBA (CDC).
Një kërcënim i madh për shëndetin publik
Infeksionet janë të vështira për t’u trajtuar sepse Candida auris është rezistente ndaj shumë ilaçeve ekzistuese antifungale. "Kur dikush i infektuar me të dhe hyn në spital, është një makth për ne", tha Casadevall.
CDC e shpalli atë si një kërcënim të madh për shëndetin publik dy vjet më parë.
Megjithëse specie të lidhura të kërpudhave janë gjetur në bimë dhe përreth sipërfaqeve të ujit, Candida auris deri më tani nuk është gjetur në natyrë.
Casadevall dhe kolegët e tij sugjeruan më parë se rritja e temperaturave të shkaktuara nga ndryshimi i klimës mund të kishte bërë që Candida auris të përshtatet me temperaturat më të larta në natyrë. Kjo mund të ketë lejuar që ky mikrob të kalojë në trupin e njeriut.
Të inkurajuar nga kjo hipotezë, autori kryesor i studimit Dr. Anuradha Chowdhary, një mikolog në Universitetin e Delhit dhe kolegët e saj analizuan mostrat e tokës dhe ujit nga tetë vende në Ishujt Andaman, një arkipelag i largët tropikal midis Indisë dhe Mianmarit.
Nëse konfirmohet se kërpudhat erdhën nga natyra dhe se ngrohja globale kishte një ndikim në kalimin e saj te njerëzit, do të ketë shqetësim në rritje që patogjenë të tjerë mund të bëjnë të njëjtën gjë.
Organizmat e shumtë të kërpudhave janë të dëmshëm për insektet dhe amfibët, por jo për njerëzit për shkak të temperaturës së lartë të trupit.
"Nëse supozimi ynë konfirmohet, ne do të duhet të fillojmë të hartojmë patogjenë të tillë në mënyrë që të mos na befasojmë pasi ishim të befasuar nga coronavirusi i ri", përfundoi Casadevall. /Telegrafi/